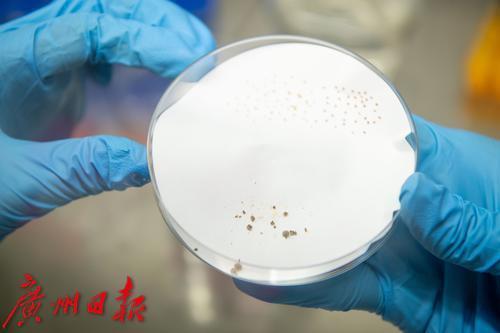

时下,当我们品尝甘甜的荔枝时,应该很少有人会思考“荔枝从哪里来?荔枝是什么?荔枝将往哪里去?”这类老学究式的哲学问题。但这“灵魂三问”,实则蕴藏着重大的科技使命,成为科学家重要的研究对象。
自2009年开始,国家荔枝龙眼产业技术体系首席科学家、华南农业大学园艺学院院长胡桂兵教授通过荔枝全基因组测序的方法,经过13年努力,确定荔枝的祖先来自123万年前的云南红河州,并由此打开了荔枝分子育种的“新大门”。
胡桂兵说,基于分子标记的分子育种技术和传统育种技术相比,就如同计算器和算盘一样的差别,能大大提高育种效率,预计再过5~10年,由分子育种技术带来的荔枝新品种就有望问世。
本期《科技周刊》,我们来到位于华南农业大学的国家瓜果改良中心荔枝分中心,一探荔枝育种的科技最前沿。

仙桃荔果园。

仙桃荔。

胡桂兵教授和他培育出的仙桃荔。

仙桃荔。


同学们自己种的荔枝。

同学们自己种的荔枝。

同学们自己种的荔枝。

实验器材。

胡桂兵教授观察实验结果。

产生再生植株。


胡桂兵团队的学生在实验室里观察培育情况。

诱导出胚芽愈伤组织和体细胞胚。

花药诱导产生愈伤组织。

胡桂兵团队的学生在实验室里观察培育情况。

产生再生植株。

花药诱导产生愈伤组织。

胡桂兵团队的学生在实验室里进行荔枝花药离体再生。

荔枝花药离体再生。

胡桂兵团队的学生在实验室里进行荔枝花药离体再生。
文/广州日报新花城记者:武威
图/广州日报新花城记者:李波
视频/广州日报新花城记者:李波、武威
广州日报新花城编辑:刘宇














































